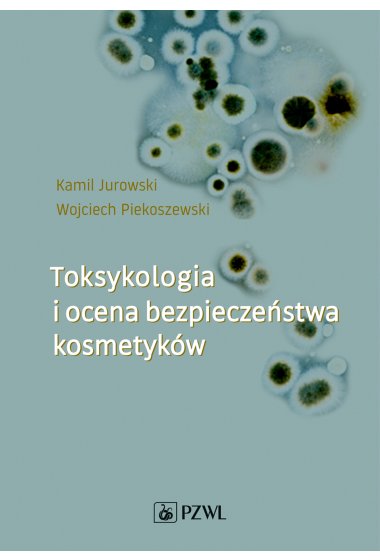

| Wydawnictwo: | PZWL |
| ISBN: | 9788320056853 |
| Numer wydania: | wydanie 1 |
| Data premiery: | 30.04.2019 |
| Format: | 165 mm x 235 mm |
| Oprawa: | miękka |
| Ilość stron: | 465 |
Książka, jakiej jeszcze nie było na polskim rynku wydawniczym! Autorzy w sposób kompleksowy przedstawiają aspekty zarówno
...
Zobacz cały opis